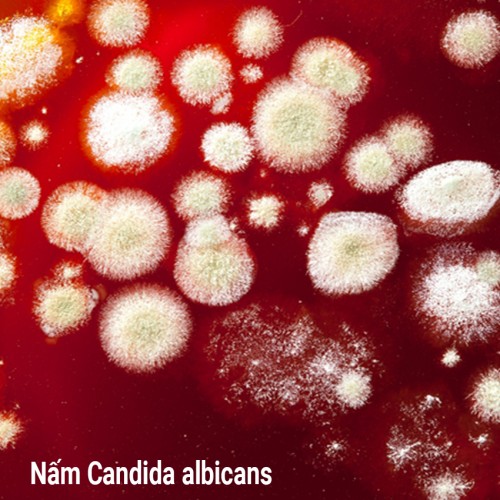

Vag-Lotuzol, Thuốc trị viêm âm đạo hỗn hợp được bác sĩ sản khoa tin dùng
- Dòng sản phẩm: Viên đặt phụ khoa điều trị viêm âm đạo hỗn hợp
- Điểm thưởng: 5
- Số lượng sản phẩm trong kho: 286
-
98.000 VNĐ
- Giá điểm thưởng: 5
VAG-LOTUZOL THUỐC TRỊ VIÊM ÂM ĐẠO HỖN HỢP ĐƯỢC BÁC SĨ SẢN KHOA TIN DÙNG
Công Thức:
Mỗi viên đặt âm đạo có chứa:
Clotrimazole ...................................................... 100 mg
Metronidazole ..................................................... 500mg

Vag-Lotuzol tác động hiệp lực điều trị hiều quả viêm âm đạo hỗn hợp.
Các đặc tính dược lý:
Tính chất dược lực học:
Clotrimazole là một dẫn chất imidazole với hoạt phổ rộng chống nấm. Chất này tác động chống nấm do ức chế tổng hợp Ergosterol, quá trình ức chế này dẫn đến tổn thương về cấu trúc và chức năng của màng tế bào nấm..
Clotrimazole có hoạt phổ chống nấm rộng rãi in vitro và in vivo bao gồm Candida Albicans, các nấm da, men, mốc….
Ngoài tác dụng chống nấm, Clotrimazole còn tác động đến Trichomonas Vaginalis, các vi khuẩn gram dương (liền cầu/tụ cầu khuẩn) và gram âm (Bateroides/ Gadnerella Vaginalis). Nó không làm ảnh hưởng tới lactobacilli.
Metronidazole là một tác nhân kháng khuẩn thuộc họ Nitro-5-imidazole. Nó tác động đến một loạt rộng rãi các vi khuẩn gây bệnh đặc biệt là các loài Bacteroides, Clostridia, Eubacteria, Fusobacteria, Gardnerella Vaginalis, và các cầu khuẩn kỵ khí, Balantidium Coli, Entamoeba Histolytica, Giardia Lamblia và Trichomonas.
Tính chất dược động học:
Sau khi đặt âm đạo, thuốc ít được hấp thu toàn thân, chủ yếu có tác dụng tại chỗ. Thuốc được đào thải qua cơ chế tự lọc sạch đường âm đạo.

Vag-Lotuzol được Bác sĩ Sản khoa tin dùng trong điều trị viêm âm đạo hỗn hợp.
Chỉ định:
Được dùng trong điều trị viêm âm đạo hỗn hợp gây ra bởi nhiễm nấm Candida Albicans, Trichomanos Vaginalis, Gardnerella Vaginalis và các vi khuẩn kỵ khí thường gặp ở âm đạo.
Liều lượng và cách dùng:
Đặt vào âm đạo 1 viên lúc trước khi đi ngủ trong 10 đêm liền hoặc trong thời gian do bác sĩ chỉ định.
Chống chỉ định:
Quá mẫn với thành phần của thuốc, tiền sử loạn tạo máu, bệnh ở hệ thần kinh trung ương, ba tháng đầu của thai kỳ.
Tác dụng không mong muốn:
Hiếm gặp những bệnh nhân có thể trải qua cảm giác nóng rát hoặc kích thích nhẹ tại chỗ ngay khi dùng thuốc này. Rất hiếm gặp những bệnh nhân thấy kích ứng này quá khó chịu và phải dừng điều trị.
Hãy thông báo cho bác sỹ bất kỳ tác dụng không mong muốn nào gặp phải khi sử dụng thuốc.
Sử dụng cho phụ nữ có thai và cho con bú:
- Phụ nữ có thai: Metronidazole không được khuyến cáo dùng trong 3 tháng đầu của thai kỳ. Mặc dù các nghiên cứu ở súc vật không cho thấy tác hại trực tiếp với việc mang thai, sự phát triển của phôi/ bào thai hoặc sự phát triển ở súc vật sơ sinh sau khi sinh.
- Phụ nữ cho con bú: Metronidazole có thể đi vào sữa, nên ngừng cho con bú khi dùng thuốc.
Đóng gói: Hộp 1 vỉ x 10 viên đặt âm đạo.
Bảo quản: Bảo quản nơi khô mát ở nhiệt độ không quá 300C.
Nhà sản xuất: Medipharco Tennamyd (Liên doanh Canada-VN).
Lưu ý:
-Bệnh nhân cần sử dụng phối hợp với các sản phẩm vệ sinh phụ nữ nguồn gốc thiên nhiên, có pH phù hợp trong điều trị viêm âm đạo, xem thêm tại đây.
-Tham khảo thêm các sản phẩm khác cùng nhóm:
OVULE BLUE hỗ trợ tăng cường sức khỏe sinh sản cho phụ nữ vô sinh hiếm muộn.
Sản phẩm liên quan
Xu hướng tìm kiếm: Vag-Lotuzol, Thuốc trị viêm âm đạo hỗn hợp, viêm âm đạo, nắm âm đạo, ngứa âm đạo, viên đặt phụ khoa, ngứa âm đao là bệnh gì, trị tận gốc bệnh nấm vùng kín, viêm vùng kín, nấm candida có tự khỏi không, nấm candida ở nữ, viêm nhiễm vùng kín, cách trị viêm âm đao, viêm âm đạo do nấm
.jpg)

![[FREESHIP + QUÀ TẶNG 39K] Dung dịch tắm gội thảo dược BLUE BABY 2.1 tắm gội cho bé, có nguồn gốc từ THẢO DƯỢC THIÊN NHIÊN. An toàn với làn da nhạy cảm của bé., tặng kem trị nhiễm trùng da trị giá 39K [FREESHIP + QUÀ TẶNG 39K] Dung dịch tắm gội thảo dược BLUE BABY 2.1 tắm gội cho bé, có nguồn gốc từ THẢO DƯỢC THIÊN NHIÊN. An toàn với làn da nhạy cảm của bé., tặng kem trị nhiễm trùng da trị giá 39K](https://www.suckhoevasacdep.health.vn/image/cache/catalog/Products/Blue Baby/Blue baby 7-300x300.jpg)
![[FREESHIP + QUÀ 49K] Loturelle Gentle Cleansing Gel – Gel tắm dịu êm cho da nhạy cảm, hương thơm bền lâu, hiệu quả cho trường hợp mụn trứng cá ở lưng được Bác sỹ Da liễu khuyên dùng – Tặng cream chống nhiễm khuẩn da trị giá 49K [FREESHIP + QUÀ 49K] Loturelle Gentle Cleansing Gel – Gel tắm dịu êm cho da nhạy cảm, hương thơm bền lâu, hiệu quả cho trường hợp mụn trứng cá ở lưng được Bác sỹ Da liễu khuyên dùng – Tặng cream chống nhiễm khuẩn da trị giá 49K](https://www.suckhoevasacdep.health.vn/image/cache/catalog/Products/Loturelle/Visa-Gel-tam-cho-da-nhay-cam-huong-thom-ben-lau-hieu-qua-cho- mun-trung-ca-o-lung-11-300x300.jpg)


